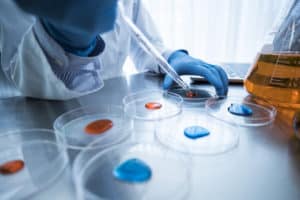

The Autism Research Institute (ARI) conducts, sponsors, and supports research on the underlying causes of, and treatments for, Autism Spectrum Disorders (ASDs). In order to provide parents and professionals with an independent, unbiased assessment of causal and treatment efficacy issues, ARI seeks no financial support from government agencies or drug manufacturers.
The Autism Research Institute (ARI) conducts, sponsors, and supports research on the underlying causes of, and treatments for, Autism Spectrum Disorders (ASDs). In order to provide parents and professionals with an independent, unbiased assessment of causal and treatment efficacy issues, ARI seeks no financial support from government agencies or drug manufacturers.
We therefore rely on the generosity of donors so that we may continue to advance autism research. Our founder Dr. Bernard Rimland would often say, ‘Research that makes a difference!’ to remind us of the need to focus on what might be beneficial here and now for people with ASDs.
2016
A Quantitative Study of Pyramidal Cells and Interneurons in the Cerebral Cortex
Manuel F. Casanova, M.D., University of South Carolina, Greenville, South Carolina
The aim of this study is to address whether Shank3 plays non-synaptic roles within the developing neocortex and whether these functions might be impaired in either autism or schizophrenia. We hope to determine whether Shank3 knockout or haploinsufficiency leads to identifiable neocortical malformations, such as a range of dysplasias, ectopias, and heterotopias, findings which have been reported in 92-100% of postmortem autistic cases.
We plan to conduct quantitative methods measuring dysplastic processes, such as minicolumnar measurements of columnar width, compactness, mean cell spacing, and peripheral neuropil space. In addition, we will also perform immunofluorescent and immunohistochemical microscopy to study patterns of mature neuronal markers (e.g., NeuN), to look for markers of immaturity (a finding sometimes reported in dysplasia), and to study variable patterns in filamentary markers across the larger expanse of neocortex. Numerous sections will also be assessed for indications of misplaced cells (heterotopias, ectopias).
Detection of a Toxin-Producing Clostridium in the Gut Flora of Autistic Children
Sydney M. Finegold, M.D., Staff Physician, Infectious Diseases Section, VA Greater Los Angeles Healthcare System, Emeritus Professor of Medicine, UCLA School of Medicine, Emeritus Professor of Microbiology, Immunology, & Molecular Genetics, UCLA
Microbiological studies revealed a higher incidence and higher counts of clostridia in autism samples compared to control samples and a significantly reduced overall bacterial diversity in the feces of the autistic group children. Research includes quantitative, selective anaerobic culture from stool specimens of children diagnosed with autism and control children.
Mitochondrial Dysfunction and Autism Spectrum Disorders-Inflammatory Subtype
Harumi Jyonouchi, M.D., Saint Peter’s University Hospital, New Brunswick, New Jersey
and Richard Frye, M.D., Arkansas Children’s Hospital Research Institute, University of Arkansas for Medical Sciences
One aim of the study is to assess the mitochondrial respiratory capacity as a marker of mitochondrial dysfunction in ASD subjects with clinical features, indicating a role of immune-mediated inflammation. The assays will be conducted utilizing peripheral blood mononuclear cells (PBMCs). The comparison (control) group will involve ASD and non-ASD case controls. The second aim of the study is to assess adaptive and innate immune function in the ASD children with clinical features that may indicate immune-mediated inflammation. At the time of assessing mitochondrial dysfunction, functional assays for adaptive and innate immune responses will be analyzed using PBMCs and purified peripheral blood monocytes. The same controls subjects will be used. Analyses will examine if there is any association between mitochondrial function and immune workup results.
Preliminary results indicate a close association between production of IL-1ß by peripheral blood monocytes and PBMC mitochondrial functions.
Clinical Trial of Suramin to Treat Autism
Robert Naviaux, M.D., University of California, San Diego (UCSD) School of Medicine, Mitochondrial and Metabolic Disease Center
This project will be the first in a series of human clinical trials to test the safety and efficacy of antipurinergic therapies in autism spectrum disorders (ASD). The first study will be small, double-blind, placebo-controled, phase I/II randomized clinical trial designed to answer two questions: (1) What domains of autism function are most responsive to single-dose treatment with suramin? (2) Are there any safety concerns?
Each child will receive a full neurological examination performed by a board-certified Pediatric neurologist at the beginning and end of the study. All testing will be done at 3 times: before (A), 2-days after (B), and 45-days after (C) a single IV infusion of suramin or saline. The reciprocal social interaction domain score of ADOS, and clinical global improvement (CGI) scales will be the primary outcome measures. NextGen metabolomics will be performed to measure about 500 metabolites in 60 biochemical pathways to identify the pathways that respond to treatment and to identify any biochemical evidence of toxicity. Other metrics will be used to study age-appropriate, normal childhood behaviors. Examples of metrics include aberrant behavior checklist (ABC), repetitive behavior questionnaire (RBQ), and autism treatment evaluation checklist (ATEC). Blood and urine will be collected for basic labs and suramin pharmacokinetics at each of the 3 time points.
The Role of the Intestinal Microbiome in Children with Autism
Harland Winter, M.D., Director, Pediatric Inflammatory Bowel Disease Center, Masachusetts General Hospital for Children
The goal of this grant is to collect of samples of blood, stool and mucosal samples from the gastrointestinal tract of 20 ASD and 20 control participants. In addition, metabolomic and microbiome analyses will be conducted on these samples.
2017
Maternal dysbiosis at birth as a model for increased risk of autism
Paul Ashwood, Ph.D., Dept. of Medical Microbiology and Immunology UC Davis School of Medicine
Our overall hypothesis is that microbiota dysbiosis in gestation will perturb microbiota transfer to the offspring, leading to intestinal dysbiosis that contributes to intestinal pathology, inflammation, and autism relevant behaviors. The long-term objectives are to assess whether the alteration of maternal microbiota will result in long-term changes in microbiota composition in the offspring, altered local intestinal barrier function, increased neuroinflammation and altered behavioral outcomes.
Mitochondrial Dysfunction Associated with Autism: Clinical Signals and Treatment Outcomes
Margaret Bauman, M.D., Boston University School of Medicine
Review the medical records of 12 ASD patients with biopsy proven mitochondrial dysfunction, ages 6-25 years of age, followed by the Integrated Center for Child Development (ICCD) (Bauman) and by the Cleveland Clinic Foundation (Natowicz) with regard to their clinical presentation, laboratory studies including blood, genetic and histopathologic findings and with regard to their developmental and medical outcomes as the result of having received the mitochondrial cocktail and carnitine.
Enhancement of tissue procurement from individuals with ASD
Thomas Blanchard, Ph.D., University of Maryland Brain and Tissue Bank
The goal of this 3 year proposal from the Maryland Brain and Tissue Bank is to identify additional medical examiners at national and state association meetings and to educate the public and medical examiners about the critical importance of tissue donations from individuals with ASD and matching controls for continued research into the etiology of autism
Atypical tryptophan metabolism is related to autism characteristics: Development of plasma and urine biomarkers
Richard Frye, MD, Ph.D. and Stepan Melnyk, Ph.D., Arkansas Children’s Hospital Research Institute
This proposal will employ state-of the-art metabolomics to investigate abnormalities in tryptophan metabolism in plasma from 157 children with ASD compared to 52 healthy typically developing controls. Preliminary evidence found that children with ASD and refreactory epilepsy had a unique metabolic peak identified as N-methyltryptamine that was not present in any of the control children or children with ASD without epilepsy.
Elevation of methionine sulfoxide in children with autism
Jill James, Ph.D. and Stepan Melnyk, Ph.D., University of Arkansas for Medical Sciences
In preliminary metabolomic studies, the oxidized form of methionine, methionine sulfoxide was found to be elevated in children with autism relative to their siblings and unrelated controls. Incorporation of the oxidized form of methionine during protein synthesis can result in damaged protein function. This proposal will extend and confirm this finding with plasma previously collected from 50 ASD/ sibling/control trios and determine the extent to which this marker of oxidative stress is related to other markers of protein damage.
Gender Dimorphism: Microbiome Analysis in Autistic Boys and Girls
Rafail Kushak, Ph.D., Dr. Sc., Massachusets General Hospital, Harvard Medical School
This proposal will test a new hypothesis suggesting that differences in the intestinal microbiota may underlie the well established male preponderance in ASD. Because intestinal microbiota is partially derived from the mother during vaginal birth, the microbiome of girls and boys with ASD and their mothers will be analyzed. This is the first study of its kind.
Transgenerational transmission of the behafolate receptor
Edward V. Quadros, Ph.D., Dept. of Medicine SUNY Downstate Medical Center Brooklyn, NY
Folate is essential for fetal as well as neonatal brain development. Folate receptor alpha (FRα) is the primary transporter of folate across the placenta to the fetus and across the choroid plexus, to the brain. Autoantibodies (AuAb) against this protein are significantly associated with developmental disorders including autism spectrum disorders. Folinic acid treatment in these children has shown improvements in language and other core deficits. The neurodevelopmental consequences of exposure to FRα antibodies (Ab) have been demonstrated in a rat model whereby pups exposed to the Ab during gestation and/or weaning have severe functional abnormalities such as socialization, communication, learning and cognitive deficits. These deficits were prevented by treatment with folinic acid. Our goal is to investigate the heritability of the behavioral phenotype in FRαAb exposed rats to determine transgenerational transmission of the phenotype and devise strategies to prevent this.
To study CREB and Akt after zinc therapy
A.J. Russo, Ph.D., Hartwick College, Oneonta, New York
The PI has previously demonstrated that the transcription factor CREB and the protein kinase AKT are low in children with autism. In this proposal, the PI will determine or not zinc therapy in children with autism will significantly raise both AKT and CREB levels in plasma and whether this increase will be associated with improved autism symptom severity in 50 children with autism and 50 age/ gender matched neurotypical children.
To assess MAPK pathway intracellular biomarkers in individuals with autism
A.J. Russo, Ph.D., Hartwick College, Oneonta, New York
This research project is designed to determine whether or not dysrugulation of MAPK/ERK pathways, specifically over-activation and under-activation in lymphocytes, can be associated specific sub-populations of autism basedon symptom severity. The PI proposes to use a MAPK phosphorylation array to measure 17 pathway biomarkers and compare these marker concentrations with severity of 19 ASD symptoms.
The role of the intestinal microbiome in children
Harland Winter, M.D., Rafail Kushak, Ph.D. and Timothy Buie, M.D., Harvard Medical School and Massachusets General Hospital
This grant will support the continued enrollment of children with autism and neurotypical controls into the Harvard/MassGeneral Hospital’s biorepository of blood and gastrointestinal tissue samples. Samples will be used for their own research and shared with other researchers who are pursuing novel and creative approaches to understand causes of autism and potential treatment options

